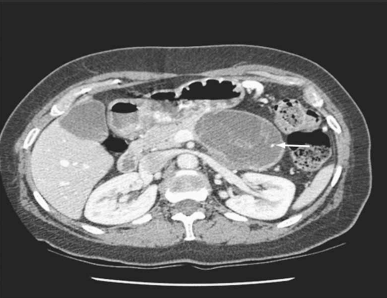
Enunciado 4099950-1

Foram encontradas 1.010 questões.
Mulher de 39 anos procurou atendimento por dor abdominal vaga, de fraca intensidade, há 4 meses. No exame físico, detectou-se uma massa abdominal de limites imprecisos e pouco dolorosa. Foi solicitada tomografia abdominal (imagem demonstrada). O exame histológico do material colhido por punção aspirativa com agulha fina revelou níveis baixos de amilase, presença de células ricas em mucina e estroma similar ao do ovário. O diagnóstico da paciente é:
(TOWNSEND JR., C. M.; BEAUCHAMP, R.D.; B. EVERS, M. AND MATTOX, K.L. SABISTON - Tratado de Cirurgia. 20ª Edição, Ed. Elsevier, 2019, Cap. 55, pg. 2395)
Provas
A condição denominada Hemosuccus pancreaticus é causada por:
Provas
Com relação à perfuração esofágica, assinale a alternativa correta.
Provas
Homem de 24 anos foi submetido a uma laparotomia exploradora (trauma fechado) e, após o procedimento, e durante o inventário da cavidade, a equipe cirúrgica encontrou o achado demonstrado na foto, localizado no íleo, a 50 cm proximal à válvula ileocecal. Trata-se de um(a):

(Fonte: arquivo pessoal dos autores)
Provas
Homem, 68 anos de idade, trazido pelo SAMU (suporte básico), apresentou parada cardiorrespiratória durante evento esportivo e foi transferido ao Pronto-Socorro, recebendo suporte básico de vida durante todo o trajeto (aproximadamente 10 minutos). Ao dar entrada na sala de emergência, sua avaliação inicial mostrou: vias aéreas pérvias, mantendo-se, pela equipe de atendimento pré-hospitalar, ventilação com bolsa-valva-máscara com oxigênio a 100%, expansibilidade torácica presente bilateralmente, sem pulso central palpável. Ao mesmo tempo, instalou-se a monitorização cardíaca e observou-se o seguinte ritmo:

As condutas a serem tomadas na sala de emergência pela equipe médica deverão ser:
Provas
Sua utilização no trauma surgiu com um grande ensaio prospectivo internacional (CRASH-2), bem como de um grande grupo retrospectivo de vítimas de combate. Pode ser útil na abordagem terapêutica de vítimas de hemorragia por trauma, desde que aplicado até 3 horas após o evento, e parece ser particularmente útil na presença de extensa fibrinólise, que pode ser avaliada pelo tromboelastograma (TEG).
Essas afirmações estão relacionadas ao seguinte fármaco:
Provas
Com relação às queimaduras, assinale a alternativa correta.
Provas
Mulher de 34 anos, vítima de tentativa de estrangulamento, deu entrada na emergência apresentando intensa dificuldade respiratória, rouquidão, estridor laríngeo, enfisema subcutâneo cervical e fratura palpável na região anterior do pescoço.
Saturação O2: 88%; FR: 22 mrpm; PA: 125/75 mmHg; FC: 108 bpm. Demais segmentos do corpo sem lesões. A suspeita diagnóstica e conduta a ser tomada na sala de emergência são, respectivamente:
Provas
Homem de 16 anos, pardo, procurou o ProntoSocorro com queixa de dor abdominal há uma semana. Duas semanas antes da consulta, tinha apresentado quadro de dor abdominal difusa, em cólica, de grande intensidade, que cedeu ao antiespasmódico aplicado em outro serviço. Passou uma semana apresentando dores leves, esporádicas. Na semana anterior, a dor voltou e como não apresentou melhora com a mesma medicação utilizada no primeiro episódio, buscou atendimento médico. Referia dois episódios de vômitos no dia da consulta, com saída de sangue na evacuação diarreica. Negava febre, negava história de dor abdominal anterior à relacionada a esta consulta, negava comorbidades. Ao exame físico abdominal apresentava dor à palpação profunda de fossa ilíaca direita, dor à descompressão brusca abdominal, sem visceromegalias, sem massas ou tumorações palpáveis. Uma peculiaridade do exame era que, à palpação da fossa ilíaca direita, não se palpavam alças. Exames laboratoriais e radiografias abdominais não mostraram alterações. Foi internado para investigação diagnóstica e submetido a exame contrastado (demonstrado na imagem). O diagnóstico do paciente é:

(Fonte: Dr. Melvyn H. Schreiber, The University of Texas Medical Branch, Galveston, TX)
Provas
Com relação aos sinais e sintomas da doença diverticular dos cólons, assinale a alternativa correta.
Provas
Caderno Container